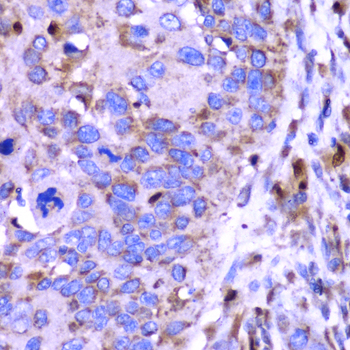

For quotations, please use our online quotation form, and you may also contact us by
service@kendallscientific.com
+1-888.733.6849 (Toll-free)
+1-617.299.7367 (Int’l))
+1-888.733.6849
Our customer service representatives are available 24 hours, Monday through Friday to assist you.| Reactivity | Human Mouse Rat |
| Tested applications | WB IHC |
| Recommended Dilution | WB 1:500 - 1:2000 IHC 1:50 - 1:200 |
| Calculated MW | 35kDa |
| Observed MW | Refer to Figures |
| Immunogen | Recombinant protein of human SPARC |
| Storage Buffer | Store at -20℃. Avoid freeze / thaw cycles. Buffer: PBS with 0.02% sodium azide, 50% glycerol, pH7.3. |
| Synonym | ON; |

Western blot analysis of extracts of various cell lines, using SPARC antibody.

Immunohistochemistry of paraffin-embedded rat Intestine using SPARC antibody at dilution of 1:100 (400x lens).

Immunohistochemistry of paraffin-embedded human lung cancer using SPARC antibody at dilution of 1:100 (400x lens).

Immunohistochemistry of paraffin-embedded human liver cancer using SPARC antibody at dilution of 1:100 (400x lens).
Immunohistochemistry of paraffin-embedded human esophageal cancer using SPARC antibody at dilution of 1:100 (400x lens).

Immunohistochemistry of paraffin-embedded mouse liver using SPARC antibody at dilution of 1:100 (400x lens).

Immunohistochemistry of paraffin-embedded mouse kidney using SPARC antibody at dilution of 1:100 (400x lens).
SPARC (secreted protein acidic and rich in cysteine), also known as osteonectin and BM40, is a secreted matricellular glycoprotein that belongs to a group of functionally related glycoproteins that includes tenascins C and X, thrombospondins 1 and 2, and osteopontin (1). Members in this class of glycoproteins are involved in tissue renewal, tissue remodeling, and embryonic development and work by exerting counter-adhesive and antiproliferative effects that lead to changes in cell shape, disruption of cell adhesion, and inhibition of the cell cycle (2). SPARC is expressed at high levels in bone tissue but is widely distributed in many other tissues and cell types (3), and is known to be associated with tissues undergoing morphogenesis, angiogenesis, mineralization, and other pathological responses to injury and tumorigenesis (4,5). SPARC has also been linked with obesity and diabetes (6).
N/A